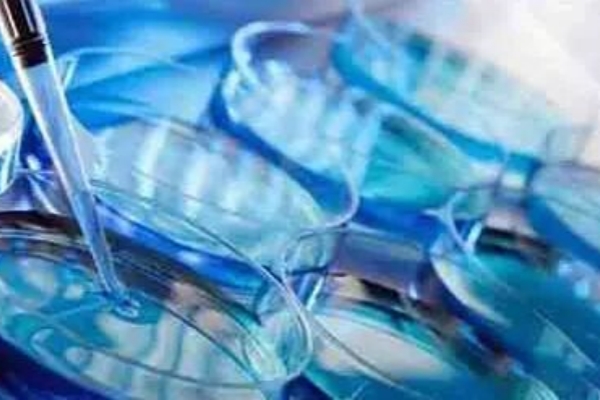

美国试管婴儿技术以高成功率闻名全球,但这一成果并非仅依赖先进的医疗设备,更与患者自身的准备、医疗团队的专业性及个性化方案密切相关。若想最大化提升成功率,以下关键点需重点关注。
一、精准评估卵巢功能,制定个性化促排方案
卵巢储备功能(如AMH值、窦卵泡数)是决定试管成功率的核心指标。美国生殖中心会通过三维超声、激素六项等全面评估卵巢状态,结合患者年龄、体重、既往病史,制定“量体裁衣”的促排方案。例如,对于卵巢功能衰退者,采用微刺激或自然周期方案,减少药物刺激对卵巢的损伤;对于多囊卵巢综合征患者,则通过降调节药物控制卵泡过度发育,避免卵巢过度刺激综合征(OHSS)。
二、优化胚胎培养环境,提升囊胚形成率
胚胎质量直接影响移植成功率。美国实验室采用国际领先的胚胎培养技术,如时差成像培养箱(可模拟子宫环境)、单精子注射技术(ICSI)及胚胎植入前遗传学筛查(PGS/PGD),确保胚胎发育潜力最大化。数据显示,囊胚移植成功率比卵裂期胚胎高30%以上,因此美国医生通常建议将胚胎培养至第5-6天(囊胚期)再移植,同时通过PGS筛选染色体正常的胚胎,将流产率降低至5%以下。
三、重视子宫内膜容受性,把握“种植窗口期”
子宫内膜厚度(8-12mm为佳)、形态(A型最佳)及血流信号是胚胎着床的关键。美国医生会通过超声监测子宫内膜变化,并结合子宫内膜容受性分析(ERA)技术,精准定位“种植窗口期”(即子宫内膜对胚胎接受性最高的24小时),确保胚胎在最佳时机植入。对于反复移植失败的患者,还可通过宫腔镜检查排除子宫内膜息肉、粘连等隐匿性病变。
四、调整生活方式,为试管周期“保驾护航”
患者自身状态对试管成功率影响显著。建议从以下方面改善:
饮食:增加蛋白质(如鸡蛋、鱼肉)、维生素(如叶酸、维生素D)摄入,避免高糖、高脂食物;
运动:每周3-5次中等强度运动(如快走、瑜伽),控制体重在BMI 18.5-24.9范围内;
心理:通过心理咨询或冥想缓解焦虑,研究显示,压力过大会降低胚胎着床率;
禁忌:移植后避免剧烈运动、提重物,禁止吸烟饮酒及接触有害化学物质。
五、成功率是“技术+细节”的双重结果
美国试管婴儿的高成功率,源于先进技术与精细化管理的结合。患者需选择经验丰富的生殖中心,积极配合医生完成全面评估,同时从生活细节入手优化身体状态。记住:试管婴儿不是“孤注一掷”的赌局,而是科学规划、医患协作的共同旅程。把握以上要点,您离成功孕育健康宝宝的梦想将更近一步!








